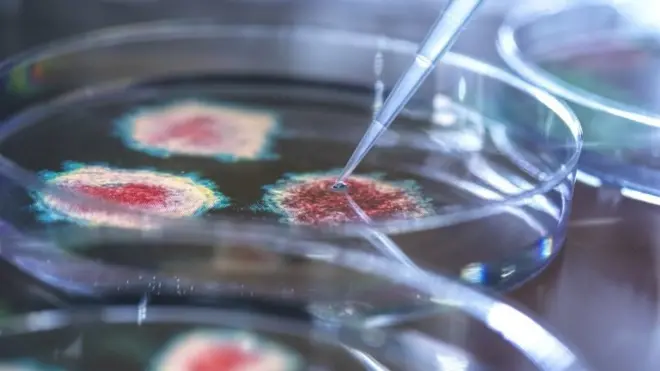
प्रयोगशालामा पेट्री डिशमा भाइरस

कोभिड खोप: कोरोना भाइरसको डेल्टा भेरिअन्टविरुद्ध पनि प्रभावकारी

तस्बिर स्रोत, Getty Images
कोभिड खोपको पूर्ण मात्रा नै भारतमा पहिले पत्ता लागेको डेल्टा भेरिअन्टबाट सुरक्षित रहन सबैभन्दा प्रभावकारी तरिका रहेको बताइएको छ।
अक्सफोर्ड-अस्ट्राजेनेका खोप सुरुमा कम प्रभावकारी भए पनि खोप लगाएको चारदेखि पाँच महिनापछि फाइजर-बायोएनटेक जति नै प्रभावकारी हुने एउटा अध्ययनले देखाएको छ।
तर यी दुवै खोप अल्फा भेरिअन्टमा जस्तो डेल्टा भेरिअन्टमा प्रभावकारी नरहेको सो अध्ययनले देखाएको छ।
नेपालमा पनि डेल्टा भेरिअन्ट फैलिएको छ।
यहाँ अस्ट्राजेनेकाको भारतीय उत्पादन कोभिशील्ड तथा जापानले दिएको अस्ट्राजेनेका, मोडेर्ना, चिनियाँ भेरोसेल र जोनसन एन्ड जोनसनका खोप दिइएको छ।
मोडेर्ना खोपको पनि यस सम्बन्धमा यथेष्ट तथ्याङ्क नभएको बताइएको छ।
तर अध्ययनकर्ताहरूले मोडेर्ना खोप पनि "कम्तीमा अन्य खोप जत्तिकै प्रभावकारी हुने" विश्वास व्यक्त गरेका छन्।
सो निष्कर्ष सात लाख ४३ हजारभन्दा बढी व्यक्तिको २५ लाख परीक्षण नतिजाको अध्ययनबाट निकालिएको हो।
अक्सफर्ड विश्वविद्यालय र यूकेको राष्ट्रिय तथ्याङ्क कार्यालयले संयुक्त रूपमा कोभिड-१९ हाउसहोल्ड इन्फेक्शन सर्भे गरेको थियो।
'धेरै बढी'
खोपको दोस्रो मात्रा लगाएको दुई सातापछि फाइजर ९३ प्रतिशत प्रभावकारी रहेको र अस्ट्राजेनेका ७१ प्रतिशत प्रभावकारी रहेको पाइएको छ।
तर समय बित्दै जाँदा फाइजरको प्रभावकारिता कम हुँदै गएको तर अस्ट्राजेनेकाको उस्तै रहेको अध्ययनले देखाएको छ।
अक्सफर्ड विश्वविद्यालयकी प्राध्यापक सारा वाकरले यो निष्कर्षले तर्सिनु नपर्ने बताएकी छन्।
उनले भनिन्, "धेरै माथिबाट सुरु गर्दा लामो बाटो जानुपर्ने हुन्छ। विश्व स्वास्थ्य सङ्गठनले प्रभावकारिताको सीमा ५० प्रतिशत राख्छ र हामी त्योभन्दा धेरै माथि छौँ।"
"यी दुवै खोपले डेल्टाविरुद्ध पनि राम्रो काम गरिरहेका छन्।"

अध्ययनका अन्य मुख्य निष्कर्षहरू यस्ता छन्:
- सङ्क्रमित व्यक्तिले खोप लगाएपछि अझ बढी एन्टिबडीहरू बनाउँछन्
- पहिलो र दोस्रो मात्रा खोपबीचको अवधिले खोपको प्रभावकारितालाई फरक पार्दैन
- वृद्धहरूमा भन्दा युवाहरू खोपले बढी सुरक्षित हुन्छन्
अध्ययनका निष्कर्षहरू यसअघिका अन्य अध्ययनहरूसँग मिल्दोजुल्दो छ। डेल्टा भेरिअन्टले सङ्क्रमण भएका व्यक्तिमा खोप लगाए पनि नलगाए पनि भाइरसको लोड उत्तिकै हुन्छ।
तर अल्फा भेरिअन्टको सङ्क्रमणमा भने खोप लगाएको व्यक्ति सङ्क्रमित हुँदा ''भाइरल लोड'' निकै कम हुन्छ।
"हामीलाई अझै पनि खोप लगाएपछि सङ्क्रमित भएका व्यक्तिले कति भाइरस सार्न सक्छन् भन्ने थाहा छैन," प्राध्यापक वाकरले भनिन्।
"उदाहरणका लागि भाइरल लोड धेरै हुँदा सार्न सक्ने सम्भावना पनि बढी हुन्छ।"
"अध्ययनको निष्कर्षले सकेसम्म धेरै मानिसहरूलाई खोप दिनुपर्ने देखाउँछ।"